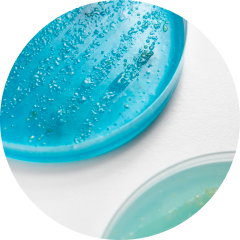

Қүнбағыс майы, кастор майы, ара балауызы, соя майы, грек жаңғағы майы, күнжіт майы, зәйтүн майы, майқарағай эфир майы, қарағай шайыры, камфора, лаванда эфир майы, эвкалипт эфир майы, изопропил метилфенол, магнолия сығындысы, токоферол, сібір эндемиктерінің сығындыларының кешені (саган-дайля сығындылары, элеутерококк, қызыл щетка, бұғы тамыры, байкал томағашөп сығындылары), шай ағашының эфир майы, шайқурай сығындысы, өгейшөп сығындысы, итошаған сығындысы, қызылкүрең сығындысы, бета-ситостерол, ментол, сквален, бал сығындысы, прополис сығындысы.
Белсенді құрамы: грек жаңғағының майы, самырсын, эвкалипт, лаванда, шай ағашы эфир майлары, қарағай шайыры, магнолия, шайқурай, өгейшөп, итошаған және эхинацея сығындылары, сібір эндемиктерінің ™ өсімдік сығындыларының кешені (саган-дайля, элеутерококк, қызыл щетка, бұғы тамыры, байкал томағашөбінің сығындылары).
(INCI): helianthus annuus (sunflower) seed oil, ricinus communis (castor) oil, cera alba (beeswax), glycine soja (soybean) oil, juglans regia (Persian walnut) seed oil, sesamum indicum (sesame) seed oil, olea europaea (olive) fruit oil, abies sibirica (Siberian fir) oil, abies sibirica (Siberian fir) turpentine, camphor, lavandula angustifolia (lavender) flower oil, eucalyptus globulus (eucalyptus) leaf oil, o-cymen-5-ol, magnolia officinalis bark extract, tocopherol, комплекс экстрактов сибирских эндемиков (rhododendron adamsii extract, eleutherococcus senticosus (eleuthero) root extract, rhaponticum carthamoides (maral root) root extract, rhodiola quadrifida extract, scutellaria baicalensis extract), melaleuca alternifolia (tea tree) leaf oil, hypericum perforatum (St. John's wort) extract, tussilago farfara (coltsfoot) leaf extract, bidens tripartita (bur-marigold) extract, echinacea purpurea (coneflower) flower extract, beta-sitosterol, menthol, squalene, honey (mel) extract, propolis extract.